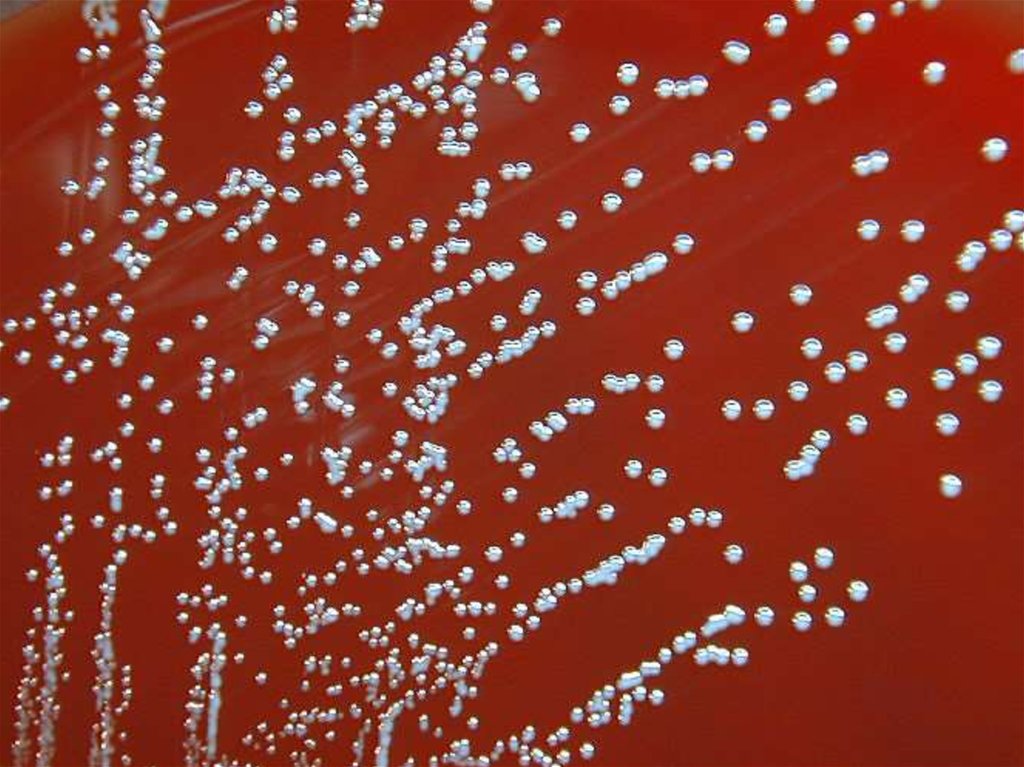

Similar presentations:
Бруцеллы. Классификация бруцелл
1. Бруцеллы
2. Классификация бруцелл
РодВиды
Brucella
B. melitensis
(3 биовара)
B. abortus
(9 биоваров)
B. suis
(4 биовара)
B. rangiferi
B. canis
B. ovis
B. neotomae
3.
4.
5.
6.
БРУЦЕЛЛЫ НА ПЕЧЕНОЧНОМ АГАРЕ7. Лабораторная диагностика бруцеллёза
Бактериологический методКровяной, печёночный
агар и др. - идентификация
Кровь, моча,
испражнения,
пунктат
костного мозга
Молочные
продукты
Биологический метод
Заражение мышей, морских свинок –
сепсис - гибель
8.
Сывороткакрови
Серологический метод
Реакции аглютинации
Хеддльсона, Райта
Аллергический метод
Проба Бюрне с
бруцеллином
9. Сибирская язва
10. Классификация
СемействоРод
Вид
Bacillaceae
Bacillus
B. anthracis
11.
12.
13.
14.
15.
16.
17.
18. Лабораторная диагностика сибирской язвы
Бактериоскопическийметод
Сыворотка
крови
Биологический метод
Заражение мышей, морских свинок,
кроликов – гибель - микроскопия
Бактериологический метод
Питательный агар («львиная грива»)
Питательный бульон («комочек ваты»)
- идентификация
19.
Выявление сибиреязвенногоантигена
Реакция Асколи
Сыворотка
крови
Аллергический метод
Проба с антраксином

medicine
medicine








